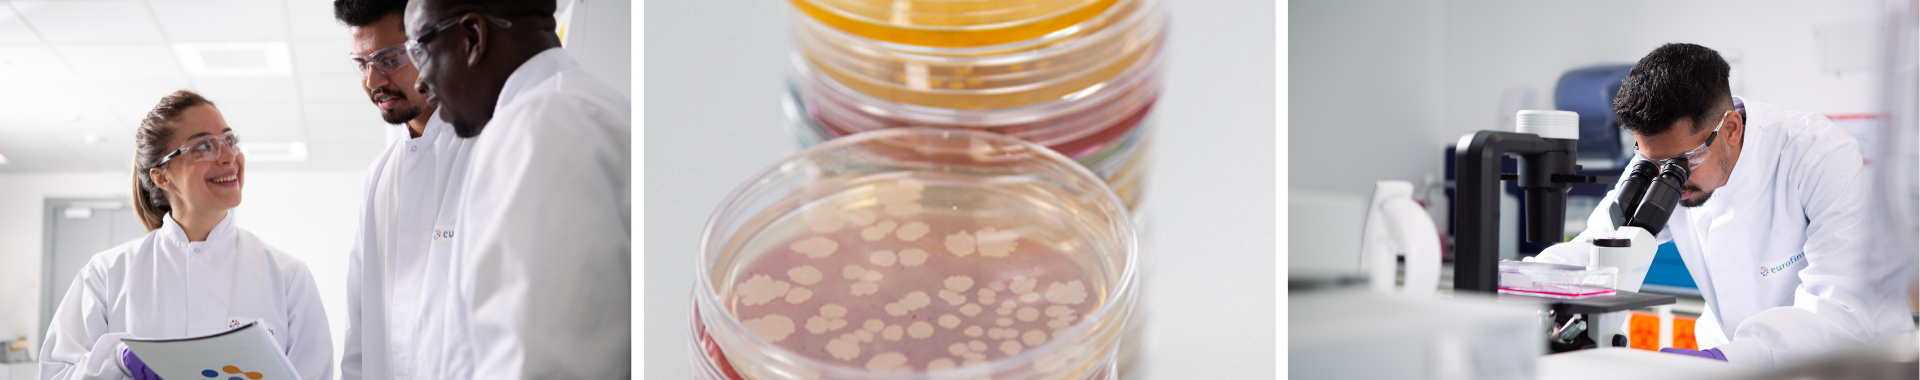
Microbiology (1)

Microbiology
|
|
Testing a wide range of samples for Total Aerobic Microbial count (TAMC), Total Yeasts and Moulds count (TYMC), and thermophiles to many different standards, as well as verification of neutralisation (method suitability) for the microbiological examination of products.
TAMC and TYMC detect the total number of bacteria, yeast and mould in a sample, and are performed to BP, EP, USP, JP and more, for:
- Bacteria (TAMC)
- Yeasts and moulds (TYMC)
- Thermophiles
Testing of method suitability using procedures that meet the harmonized pharmacopoeias USP <61> and <62>; and Ph.Eur. 2.6.12 and 2.6.13, for example:
- BS EN 21149 Cosmetics microbiology – Enumeration and detection of aerobic mesophilic bacteria.
- BS EN 16212 Cosmetics microbiology – Enumeration of yeast and mould
- BS EN 22717 Cosmetics microbiology – Detection of Pseudomonas aeruginosa
- BS EN 22718 Cosmetics microbiology – Detection of Staphylococcus aureus
- BS EN 18416 Cosmetics microbiology – Detection of Candida albicans
Presence or absence tests performed for specified organisms from a variety of source materials including food, water, consumer, household, cosmetics, toiletries and pharmaceutical medicinal products.
Testing for a most microorganisms, for example:
- Salmonella
- Enterobacteriaceae
- Coli
- aeruginosa
- aureus
- Clostridia
- Listeria monocytogenes
Use of a combination of traditional and rapid biochemical identification methods for identification, allowing assessment of risk, identification of source contamination, or preparation of contamination control strategies.
Incubation and enumeration of active air samples, settle plates and surface monitoring samples such as contact plates or swabs.
Performing the microbiological examination of samples to BP, EP, USP, JP and more, for:
- Raw Materials
- In-process samples
- Product release testing
- Medical devices
- Preservative Efficacy Testing
- Potency Assays
Testing for bacterial endotoxin of water and finished products using either:
- Gel Clot
- Turbidimetric Assay techniques
Population determinations and enumeration performed on a range of different biological indicator types, including Geobacillus stearothermophilus strips, ampoules and more to confirm the population as stated by the manufacturer, or to confirm the effectiveness of sterilisation cycles.
Microbiological testing to EP and USP assays performed to determine the potency of various:
- Antimicrobials
- Antibiotics
- Vitamins
Testing to assess the performance of a samples antimicrobial activity over a fixed period of time, either in a finished product or as a tool in formulation/product development.
Testing performed to either:
- BP
- EP 5.1.3
- USP<51>
- ISO 11930
A known high level of the organisms under study are inoculated into the product under test and thoroughly mixed.
Aliquots of the inoculated product are withdrawn at pre-defined time points and enumerated using standard microbiological techniques and reduction in population calculated by subtraction from the initial inoculum level.
Performing various tests to determine the antimicrobial properties of fabric and plastic products to a variety of regulatory standards:
- AATCC 147, Antibacterial activity assessment of textile materials parallel streak method
- AATCC Test Method 30, Antifungal activity, assessment of textile materials: mildew and rot resistance of textile materials
- AATCC Test method 100, Antibacterial finishes on textile materials: Assessment of
- ISO 22196 / JIS Z 2801, Antimicrobial products – Test for antimicrobial activity and efficacy
- ISO 20743 / JIS Z 1902, Textiles – determination of antibacterial activity of antibacterial finished products
- ISO 20645, Textile fabrics, determination of antibacterial activity – agar diffusion test
- ASTM E2149-01 Standard test method for determining the antimicrobial activity of immobilized antimicrobial agents under dynamic contact conditions